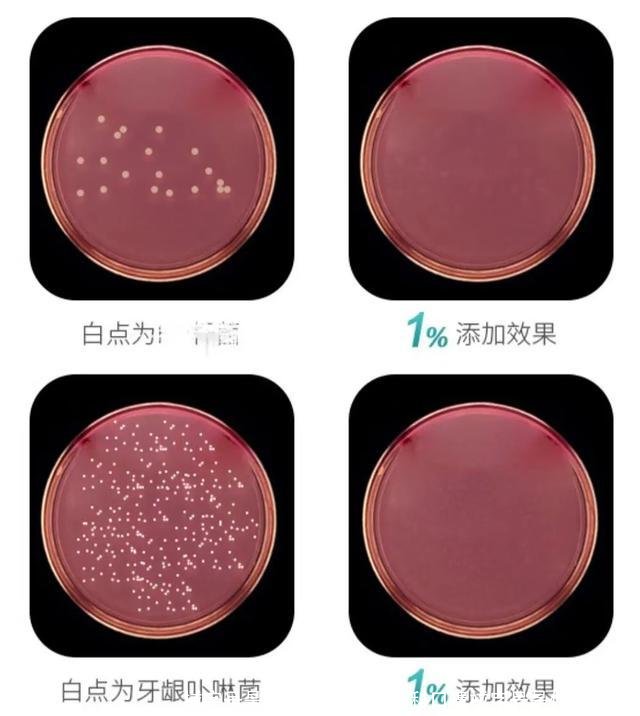
械字号是什么意思(医用外科口罩械字号是什么意思)

您现在的位置是:生活百科网 > 生活百科 >
械字号是什么意思(医用外科口罩械字号是什么意思)
2022-04-19 14:40生活百科 人已围观
简介械字号是什么意思今天开始卖大号创可贴了,医用级别加艾草械字号的。猜猜哪个是我?预防胃癌的牙膏几天前,国家药品监督管理局在其官方网站发表了一篇文章,名为牙膏不能治疗...
械字号是什么意思
今天开始卖大号创可贴了,医用级别加艾草械字号的。
猜猜哪个是我?
预防胃癌的牙膏
几天前,国家药品监督管理局在其官方网站发表了一篇文章,名为牙膏不能治疗疾病。
这篇文章提醒了广大消费者两件事,一是市面上很多宣传可以“抗幽门螺旋杆菌”的牙膏,并不是真正意义上的牙膏,这种所谓的“牙膏”用多了,不旦不能治病,反而损害口腔健康;
二是牙膏本身是不能用来治疗幽门螺旋杆菌的,不仅如此,牙膏啥病都不能治,因为它属于化妆品范畴,只有防蛀、抑牙菌斑、减轻牙龈问题等功效,治和牙齿没关系的器官属于无稽之谈。
虽然没有直接点名,但这篇文章直指市面上流行的“抗幽牙膏”。

所谓的“抗幽牙膏”,就是那些号称加入了乳铁蛋白,可以有效杀灭胃癌头号元凶——幽门螺旋杆菌的牙膏,也被称为“杀幽牙膏”。
这种牙膏一支价格通常在50元到几百元不等,虽然比普通牙膏贵出不少,但从上市起就受到了无数消费者的追捧,无外乎就是利用了人们对幽门螺旋杆菌的恐惧心理。
幽门螺旋杆菌是一种非常特殊的细菌,它在全球自然人群的感染率超过50%,在我国的平均感染率为59%,也就是说每五个人中就有可能有三个感染者。
作为一种能在强酸液体中存活的细菌,幽门螺旋杆菌是目前发现的唯一能从胃中备份里培养出来的微生物。
1983年,幽门螺旋杆菌首次从一名慢性活动性胃炎患者的胃粘膜活检组织中分离,经研究,这种细菌会造成多种胃部疾病,可能有致癌的风险,所以不少人“闻幽色变”。

尽管幽门螺旋杆菌的菌种有很多,不是每一种都需要治疗,其致癌率也要综合考虑多种因素。
但毕竟大多数人对此并不是很了解,再加上每个人都抱着这毕竟是一种细菌,总之很难把它当成“无害”的东西,“抗幽牙膏”就有了很大的市场。
不过,目前为止,这种细菌只能在人的胃部繁殖,人体的口腔还无法培养出幽门螺旋杆菌。
因此,如果想要根除幽门螺旋杆菌,靠刷牙是绝对不可能成功的,一定要去正规医院进行治疗才行。
就算是在正规医院治疗,也需要配合多种抗生素才能够根除,如果靠刷牙就能解决问题的话,医院也没必要白费力气了。
广告法里明确规定,除医疗、药品、医疗器械外,禁止任何广告涉及到治疗疾病的功效,医疗性用语都是禁止使用的。
一旦过于相信这种虚假宣传,可能会耽误正常的治疗。

因为广告法的原因,各大商家纷纷整改,不再在明面上称这种牙膏可以灭除幽门螺旋杆菌,而是打起了擦边球:
有的在页面标注幽门螺旋杆菌的英文缩写“HP”;有的在商品详情页面打了隐约可见的马赛克来暗示消费者;还有的则是在商品名上花费心机,比如什么“净幽灵”、“必幽停”
尽管官方一再打假辟谣,但这类虚假宣传的牙膏还是销量不菲。
(马赛克效果)
这类牙膏之所以能够大卖,除了人们对幽门螺旋杆菌的恐惧外,还有一个原因,就是有所谓的“械字号”背书。
有一类“械字号牙膏”,同样也打着“抗幽牙膏”的旗号,在市场上大行其道。
在说“械字号牙膏”前,先和大家解释一下什么是“械字号”。
所谓的“械字号”,是指医疗器械的备案字号。
这类产品都是风险程度低,在食药监备案后,实行国家常规管理可以保证其安全、有效的医疗器械。
相对于普通产品来说,在说明书上注明了临床功效的械字号产品,比普通产品的安全性更高,在特殊人群使用的时候也会更加安全。
日常生活中,我们接触最多的械字号产品,当属疫情期间必不可少的口罩。

械字号产品按照风险程度实行分类管理,其分为三类:
第一类是风险程度低,实行常规管理就可以保证安全、有效的医疗器械;比如日常生活中我们常见的棉签、纱布等;还有医用放大镜、手术刀、面罩等相对比较基础的产品;一般用于外用;
第二类是具有中度风险,需要严格控制管理以保证其安全、有效的医疗器械;除了管控严格的冷敷凝胶、敷料等,还包括部分艾灸贴、蒸汽眼罩等;
第三类是具有较高风险,需要采取特别措施严格控制管理,以保证期安全、有效的医疗器械;比如一些医疗美容针,需要直接植入人体内,因此需要很高的标准,才可以确保其安全。
评估其风险程度,需要考虑到这种医疗器械的预期目的、结构特征、使用方法等因素。

“械字号牙膏”在介绍商品时,都会规避掉“牙膏”的名号,而是称之为“口腔抑菌剂”、“冷敷凝胶”等。
因为牙膏类产品属于“妆字号”,而他们主推的凝胶为“械字号”。

乌鸦看到商品详情界面出现了这款凝胶的批准文号为宁苏银械备20210002号,于是去药监局官网搜索了一番,发现这款商品的实际用途和备案完全不同。
在备案中,这款冷敷凝胶是用于“人体物理退热、体表面特定部位的降温”;然而在商品详情界面,这款冷敷凝胶却是一款用来清新口气、杀除幽门螺旋杆菌的产品。
尽管在详情页面,商家说这是因为医疗器械类产品的备案必须按照冷敷凝胶大类统一来写,只要是用于人体表面就可以了。
但乌鸦在搜索过程中,也发现了一些有其他用途的冷敷凝胶,比如“保护微创手术创面”、“促进创面愈合”、“修复受损肌肤”等。
再加上对不上号的配料表,这种说法确实不太具备说服力。
还有一些“械字号牙膏”更为离谱,在备案上的用途是“颈椎病、肩周炎”,牙膏和膏药,傻傻分不清楚。

除此之外,到了2022年,这些“牙膏”在成分上也有违规的地方。
2021年12月31日,国家药监局发布了第一类医疗器械产品目录公告。
在这份公告的附录中,写明了第一类医疗器械禁止添加的成分,其中包括中药、化学药物、生物制品、消毒和抗菌成分、天然植物及其提取物等发挥药理学、免疫学、代谢作用的成分或者可被人体吸收的成分。
这句话的意思,说白了就是第一类器械就是单纯的器械,只能发挥物理作用,绝对不能用来治病。
什么薄荷、抑菌剂、维生素、酶等,都是不允许添加的。
这些“牙膏”,明显不符合条件,添加了大量的违规物。
更何况这些违规物,和治疗幽门螺旋杆菌根本没关系。

这份公告中,除了禁止添加中药、天然植物及其提取物成分外,最大的变动就是将“冷敷凝胶”“医用冷敷贴”从第一类医疗器械中删除了。
也就是说,这些“械字号牙膏”,如今已经彻头彻尾成了违规产品:既不是械字号产品,也不能治疗所谓的疾病。
不过,目前市面上依旧充斥着大量号称可以“治病”的“械字号牙膏”,在各大网购平台搜索,还都处于热销的状态。
除了不合规的“械字号牙膏”外,以第一类医疗器械备案的“械字号膏药”比比皆是,但这类产品现在也已经处于违规状态,比如常见的“仁和”“修正”“同仁堂”的冷敷贴。

长期以来,市场上的膏药大多都是“械字号”,由于“国药准字号”审批严格,而“械字号”第一类产品只需要备案就可以生产。
所以很多商家为了缩短产品的上市时间,都会选择用这类“械字号”生产。
而这些“械字号膏药”之所以畅销,一是有一众“大品牌”为之作担保;
绝大多数“械字号膏药”,都是品牌授权后贴牌生产;他们先在药监系统进行注册备案,获得批号后,就寻找品牌方进行授权,然后找厂家进行贴牌生产;许多品牌的“械字号膏药”,追根溯源都是同一个批号;
消费者出于对品牌方的信任,都会选择购买;然而有不少人在使用过程中引发了过敏、皮肤溃烂等问题,影响了治疗;

另一方面,消费者在购买时,并不是很清楚“械字号”与“国药准字号”的区别,认为同样都是医药用品,所以质量有保障,可以放心使用;
不少企业就摸准了消费者的这种心理,开始大量敛财。
敛财最成功的,当属前两年就被叫停的“械字号护肤品”,其中又以“械字号面膜”为首。
所谓的“械字号面膜”,其实是医用敷料,最初主要用于医美手术后的皮肤护理修复。

这种医用敷料和普通面膜的外观基本没有区别,再加上商家鼓吹的护肤宣传,让不少消费者也为之掏空了自己的腰包。
有的商家宣称,这些面膜可以美白、抗皱、祛痘只需一片,就能搞定所有脸部问题,被很多消费者奉为“烂脸救星”。
而实际上,这些所谓的“医用面膜”,其实都是医用冷敷贴、医用透明质酸钠修复贴、类人胶原蛋白敷料。
这些敷料的成分十分简单,一般只有胶原蛋白和简单的玻尿酸成分,并不具备美白、抗皱、祛痘等功效。

敷尔佳,“械字号面膜”的领头羊,在“医用面膜”大火之时,2019年其营收同比增长了259.44%,营收规模也由2018年的3.73亿元增长到2019年的13.42亿元。
然而这家号称“科技创新”属性的公司,在2021年之前根本就没有生产线,而是一家“贴牌公司”;
在公司人员构成上方面,截至2021年第一季度末,敷尔佳的291名员工里,仅有两名研发人员,高管中只有一名药剂师,与医疗器械、化妆品的相关性都很低;
同时其在研发的投入上也很吝啬,2018年到2020年,其研发支出分别为30.79万元、60.39万元和147.97万元,占同期营收比不足0.1%,远低于行业3.7%的平均值。
既没有核心技术,也没有专利,一家公司就凭着“械字号面膜”的招牌,靠着大量的宣传费,大发其财。

除了敷尔佳这样的公司外,还有一些品牌,用普通面膜来冒充“械字号面膜”。
众所周知,片状面膜成本低廉,所谓燕窝、胶原蛋白、金箔等,大多是噱头,面膜的主要成分都是一样的。
有些商家打着医疗美容的擦边球,用普通面膜混淆视听,让消费者“重金买安心”,其实是当了冤大头。
2020年1月2日,国家药监局发文表示,不存在“械字号面膜”,医用敷料不得宣称自己“美容”“保健”,医疗器械产品也不能称自己为“面膜”;另一边,面膜也不能称自己为“医学用”,这些都是违法行为。
不过,依旧有不少商家在违法的边缘试探。
比如敷尔佳有许多款妆字号面膜,以“修护贴”为称,宣传可以“舒缓敏感”,诱导消费者将其看作医疗器械,吸引消费者购买。

还有些公司,为了牟取暴利,不惜夸大宣传,甚至走上了传销的道路:
比如不久前朋友圈疯传的“倍视美护眼液”,号称能够被眼睛直接吸收,清除眼睛肿的毒素,缓解疲劳,对近视、干眼症、白内障等均有益处,简直是眼部“神仙水”;
另一款“爱力通共振眼镜”更为神奇,不但能预防、治疗眼部疾病,甚至还能改善鼻炎;
还有包治百病的“华盛康益冷敷凝胶”,头痛医头,脚痛医脚,心脏病灰指甲通通不在话下
其赚钱模式,更是怎么看怎么像传销。

事实上,“械字号”本身没有什么问题,但不少公司却钻空子,借着“械字号”宣传自家产品的功效,将日用品和医用品混淆,还夸大宣传,疯狂敛财。
一类械字号产品审查尺度宽松、市场广告监管不力、消费者对“械字号”概念模糊不清等原因,共同形成了“械字号产品”的灰色地带。
近年来,医疗器械虚假宣传和夸大功效的情况,无论是在线上还是线下的销售渠道,都不是什么稀奇事,就此引发的纠纷也越来越多。
一些监管机关也开展了医疗器械经营违法违规行为排查的整治行动,国家药监局也一再发文强调所谓的医疗器械都不能治病,但上当受骗的消费者还是一抓一大把。
当然,宣传教育比不过硬性标准规定,这次国家药监局将容易被钻空子的“医用冷敷料”和“冷敷凝胶”从第一类医疗器械中删除,不给你模糊地带,就是专门加大了对“械字号”的监管力度。
所谓的“械字号化妆品”、“械字号保健品”将再无生存空间。
另一边,消费者也要擦亮双眼,警惕“械字号”陷阱。
怕没用,更怕起了反作用。
简而言之就是一句话,治病认准“国药准字号”;能治病的“械字号”,十有八九都是智商税。
参考资料:
央广网:揭秘行业乱象!大量“械字号膏药”进行涉及疗效的不当宣传
红周刊:敷尔佳“械字号面膜”被禁用,突击10亿分红后再巨额募资存疑
法制日报:“医用面膜”充斥电商平台 警惕面膜类化妆品消费陷阱
聚美丽:宣称刷牙治胃病,这类企业要凉了
牙膏防胃癌,眼镜治鼻炎,“械字号”一定就有效?,预防胃癌的牙膏
相关文章
- 2023北京本科普通批985院校投档线:清华685、北大683、武大653分
- 广东考生上华南理工大学难吗?
- 上海这3所大学2023考研复试分数线公布
- 最大相差178分!南京理工大学投档线集锦!最高681分,最低503分
- 2023湖北物理类投档线:武科大573、湖大563、江大536、武体506分
- 多少分能上南大?2023南京大学在苏录取数据盘点,这些途径可以走
- 2023山东高考,省内分数线最高的十所大学
- 国防科技大学录取分数线是多少?附国防科技大学毕业去向
- 郑州大学多少分能考上?2024才可以录取?附最低分数线
- 北京航空航天大学2023年录取分数线及省排名
- 哈尔滨工业大学(威海)、(深圳)校区2023年录取分数情况
- 2023广东本科投档线出炉!请看中大/华工/深大/华师/暨大等分数线
随机图文
上海交通大学世界排名(上海交通大学世界排名多少位)
2020年6月10日,QS世界大学排名网发布了“2021QS世界大学排名”(QuacquarelliSymonds,...
修仙小说排行榜前十名(最火修仙小说排行榜前十名)
修仙小说排行榜前十名十部经典小说最近在书旗小说看了好多小说,都是免费阅...
漂白剂成分(衣服漂白剂成分)
漂白粉的有效成分是什么化学品中文名称:次氯酸钙化学品英文名称:calciumh...
国内羊奶粉十大排行榜(国产的羊奶粉哪个牌子的好啊)
选奶粉一直是妈妈们的痛点,不仅纠结于牛羊品类,而且纠结于营养偏向。为了...
抄写作文三年级(抄写作文三年级一百字)
抄写作文三年级小学生作文,老师批阅后哭笑不得:抄写100遍,爸爸看完,直接...
电脑显示屏不亮但是主机已开机(电脑显示屏不亮但是主机已开机显示无信号)
电脑显示屏不亮但是主机已开机哎,干电脑这么多年,慢慢发现越是墨迹的客户...
信用不好怎么贷款「信用不好怎么贷款app」
大家好,今天来为大家解答信用不好怎么贷款这个问题的一些问题点,包括信用...
公开招聘650名!沈阳市公安局2023年度招聘警务辅助人员公告!
为满足公安工作需要,沈阳市公安局面向社会公开招聘警务辅助人员650名,其中...